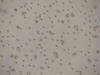
DSC09724 los angeles computer summer camp (47172 sports and computers)

Techno-tainment Camp
at Hawthorne School
Week 5
July 21-25, 2008
DAY 4: Thursday, July 24
Get ready for the best day of your life!
DAY 3: Wednesday, July 23
DAY 2: Tuesday, July 22
Remember:
Tomorrow is
3D Dress-up Day!
3 D 3 D 3 D 3 D 3 D 3 D 3 D 3 D 3 D 3 D 3 D 3 D 3 D 3 D 3 D 3 D 3 D 3 D 3 D 3 D 3 D 3 D 3 D 3 D 3 D
DAY 1: Monday, July 21